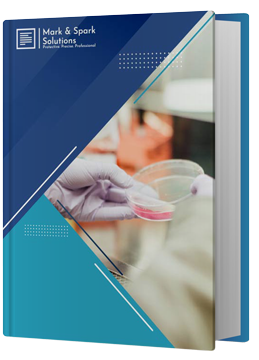

Market Outlook
The Microbial DNA Modifying Enzymes market was valued at USD 869 Million in 2024 and is projected to grow to USD 1,459 Million by 2030, with a compound annual growth rate (CAGR) of 9.3% from 2025 to 2030. The Global Microbial DNA Modifying Enzymes Market encompasses the industry focused on enzymes sourced from microorganisms that can change DNA structures through various processes like cutting, joining, adding chemical groups, or recombining DNA. These enzymes include important tools such as restriction endonucleases, DNA ligases, polymerases, and methyltransferases. They're essential in fields like molecular biology, genetic engineering, diagnostics, and synthetic biology. Researchers in academia, pharmaceutical companies, and biotech firms rely on these enzymes for tasks like gene editing, cloning, sequencing, and studying epigenetics.
The Microbial DNA Modifying Enzymes market is being driven by a growing demand for precision medicine and advanced genetic research. The rapid progress in genomics and proteomics, along with the rise of CRISPR gene-editing technologies, is broadening the use of these enzymes in both therapeutic and diagnostic applications. Furthermore, the increased affordability and availability of next-generation sequencing tools have sparked more interest in genetic engineering, leading to a higher demand for quality enzymes. Investments from both government and private sectors in biotech research and development, alongside a growing biopharmaceutical pipeline, are also fueling market expansion.
There are exciting opportunities in developing new enzymes that are more specific, stable, and efficient. With the rising interest in synthetic biology and microbiome-based therapies, there are chances to apply these microbial enzymes in unconventional areas like agriculture and environmental science. Emerging economies also present a significant potential due to the expansion of biotech infrastructures and increasing funding for academic research. Additionally, the integration of artificial intelligence and bioinformatics in the discovery and design of enzymes is poised to revolutionize the market, offering innovative solutions for complex biological processes and advancements in personalized healthcare.
Key Insights
North America accounted for the largest share of the Microbial DNA Modifying Enzymes market at 46.50% in 2024. North America is at the forefront of the global market for microbial DNA modifying enzymes, thanks to its strong research capabilities and significant investments in biotechnology. The presence of major pharmaceutical and biotech companies in the region plays a big role here, along with advanced genomic research projects and widespread use of gene editing technologies like CRISPR. Support from the government, partnerships between academic institutions and industry, and a growing emphasis on precision medicine are all contributing to the market's growth. The U.S. stands out as a leader in patent filings and clinical trials related to microbial DNA enzymes, solidifying its position on the global stage. Additionally, the rising demand for molecular diagnostics and personalized therapies is driving innovation and commercialization of these enzymes in the region.
In terms of Enzyme Type, the Pharmaceutical Grade accounted for a major share of 30.1%in 2024. The polymerases segment leads the global market for microbial DNA modifying enzymes due to its vital role in DNA replication, amplification, and sequencing. Polymerases are widely utilized in techniques such as PCR (polymerase chain reaction) and next-generation sequencing, making them essential for molecular diagnostics, genetic research, and forensic analysis. The increasing demand for personalized medicine, disease detection, and genomics research further drives the need for effective polymerases. Additionally, advancements in thermostable and high-fidelity polymerases enhance their reliability and performance, broadening their applications across the biotechnology and pharmaceutical industries. This extensive utility and ongoing innovation position polymerases as the dominant enzyme type in the microbial DNA modifying enzymes market.
Market Dynamics
Drivers:
The rapid expansion of genetic and synthetic biology projects spanning CRISPR, base editing, and microbial strain engineering drives demand for precise DNA-modifying enzymes.
The rapid growth of genetic and synthetic biology projects is driving a big demand for enzymes that modify microbial DNA. Breakthroughs like CRISPR-Cas systems, base editing, and prime editing have completely transformed how scientists edit genes, allowing for precise and effective changes at the DNA level. As a result, there's a heightened interest in various enzymes, such as restriction endonucleases, ligases, polymerases, nucleases, and methylases, which are essential for gene editing processes.
CRISPR, in particular, has become a game changer in genome editing thanks to its simplicity, scalability, and accuracy. Researchers are busy developing new microbial strains for uses in medicine, agriculture, and industrial biotechnology, which creates a solid need for high-fidelity DNA-modifying enzymes. These enzymes are crucial to ensure modifications are accurate and to minimize unwanted side effects. Additionally, techniques like base editing and prime editing provide even more precise alternatives to traditional CRISPR methods by allowing for changes at the single-nucleotide level without causing double-strand breaks. These cutting-edge tools rely heavily on specialized enzymes that can create targeted edits with minimal unintended results.
In the realm of synthetic biology, modifying microbial DNA is key to designing synthetic pathways and improving microbial cell factories that produce pharmaceuticals, biofuels, and specialty chemicals. By tweaking microbial genomes, scientists can boost productivity, stability, and resilience in engineered strains.
The surge in demand is further fueled by increased investments in life sciences research, biofoundries, and genome editing startups around the globe. This blend of technological advancements and diverse applications is expanding the market for microbial DNA-modifying enzymes, positioning it as a vital player in the future of biological engineering.
Producing recombinant microbial enzymes is expensive, limiting affordability and accessibility for smaller labs.
Creating recombinant microbial enzymes involves a series of intricate steps, including gene cloning, expressing the genes in host organisms such as E. coli or yeast, and then moving through processes like fermentation, purification, and quality control. All these steps demand specialized equipment, high-quality reagents, tightly controlled environments, and skilled personnel, which significantly drives up production costs.
For smaller labs, particularly in academic settings or developing regions, these expenses can be overwhelming, hindering their ability to obtain and utilize high-quality DNA-modifying enzymes for research or product development. Buying these enzymes from commercial suppliers adds to the burden, as there are extra costs associated with packaging, storage (like cold chain logistics), and intellectual property licensing. Consequently, many smaller laboratories encounter challenges in accessing essential tools required for advanced genetic engineering and synthetic biology, which can stifle innovation and limit involvement in groundbreaking biotechnology research.
|
Key Pointers |
Values |
|
Report Focus |
Global |
|
Largest Region |
North America |
|
Fastest Growing Region |
Asia Pacific |
|
Base Year |
2024 |
|
CAGR % (2024-2030) |
9.3% |
|
Forecast Year |
2025-2030 |
|
Historical Year |
2015-2023 |
|
Market Size in 2023 |
USD 809 Million |
|
Market Size in 2030 |
USD 1,459 Million |
|
Countries Covered |
U.S., Canada, Mexico, Germany, UK, France, Italy, Spain, Turkey, Israel, China, Japan, India, South Korea, Australia, SEA, Brazil, Chile, Argentina, Saudi Arabia, UAE, Qatar, South Africa, Rest of World |
|
Key Driver & Challenges |
Rising genetic disorder prevalence and customized microbial/agricultural solutions; booming gene therapy and advanced genome?editing technologies like CRISPR; expanding applications in diagnostics, biotechnology, and sustainable bio?products. High development/manufacturing costs; regulatory, ethical and IP hurdles; limited skilled personnel and infrastructure in emerging regions. |
|
Segments Covered |
By Enzyme Type, By Application, By End User |
Segmental Analysis
Based on Enzyme Type, Microbial DNA Modifying Enzymes market is segmented into Restriction Enzymes, Polymerases, Ligases, Nucleases, Methylases, Other Enzymes.
In the Global Microbial DNA Modifying Enzymes Market, the Polymerases segment stands out as the leader, and it's easy to see why. These enzymes play a crucial role in fields like molecular biology, biotechnology, and diagnostics. Simply put, polymerases are responsible for synthesizing DNA from its building blocks, known as deoxyribonucleotides. Among them, microbial DNA polymerases from heat-loving microorganisms are particularly popular because they're stable at high temperatures and work efficiently in reactions like the Polymerase Chain Reaction (PCR).
One big reason for the dominance of this segment is the widespread use of PCR technology in various areas such as research, diagnostics, and forensics. PCR relies on DNA polymerases like Taq polymerase to amplify specific DNA sequences, making it a standard practice in labs around the world. Furthermore, the rapid growth of next-generation sequencing (NGS) technologies has increased the demand for high-fidelity and processive DNA polymerases, which are necessary for accurate DNA replication during sequencing.
Moreover, there's been a surge in investment in genomics research, particularly in areas like personalized medicine and monitoring infectious diseases, such as COVID-19 testing. This has further boosted the need for advanced polymerase enzymes. Ongoing development of new polymerase variants that offer improved accuracy, resistance to inhibitors, and faster processing times enhances the segment's market position even more.
The polymerases segment is also thriving due to its wide range of applications across academic research and industries like pharmaceuticals, agriculture, and environmental monitoring. As the demand for reliable and efficient DNA amplification methods grows, the polymerases segment is poised to continue leading the global microbial DNA modifying enzymes market.
|
Segments |
Values |
|
By Application |
|
|
By End User |
|
Regional Landscape
In the context of regional analysis, the Microbial DNA Modifying Enzymes market includes North America, Europe, Asia Pacific, South America, and the Middle East and Africa.
The market size of the North America was valued at USD 447.5 Million in 2024 and is expected to reach USD 725.4 Million by 2030, with a CAGR of 8.6% during the forecast period. North America stands out as the leader in the global market for microbial DNA modifying enzymes, thanks to its strong biotechnology infrastructure, ample research funding, and extensive applications in genomics and molecular biology. The United States, in particular, is home to many top biotechnology and pharmaceutical firms that are deeply engaged in areas like genetic research, synthetic biology, and drug development. Institutions like the National Institutes of Health (NIH) and major universities play a key role in advancing the use of DNA modifying enzymes such as polymerases, restriction enzymes, and ligases both in academic settings and commercial ventures.
The growing demand for these enzymes in North America is also supported by a robust healthcare system and an increasing interest in personalized medicine. These enzymes are essential for next-generation sequencing (NGS), diagnostics, and gene therapy development. With a rise in chronic and genetic disorders, there’s been a surge in research efforts, further boosting the need for these crucial tools.
Additionally, the presence of major companies like Thermo Fisher Scientific, New England Biolabs, and Agilent Technologies not only makes high-quality enzyme products easily accessible but also fosters ongoing innovation in the field. These firms invest significantly in research and development to create highly specific, stable, and efficient enzymes suited for new biotechnological applications.
Government backing, strong intellectual property protections, and a supportive regulatory environment also play a vital role in maintaining North America’s leading position in this market. As a result, it is expected that North America will continue to dominate the microbial DNA modifying enzymes market, driven by technological advancements, increased commercial use, and a well-established research community.
Competitive Landscape
Some of the major companies operating within the Microbial DNA Modifying Enzymes market are: Promega Corporation, BioCat GmbH, Takara Bio Inc., Thermo Fisher Scientific Inc., New England Biolabs, Fortis Life Sciences, Agilent Technologies, Inc., Danaher Corporation, Merck KGaA and Others.